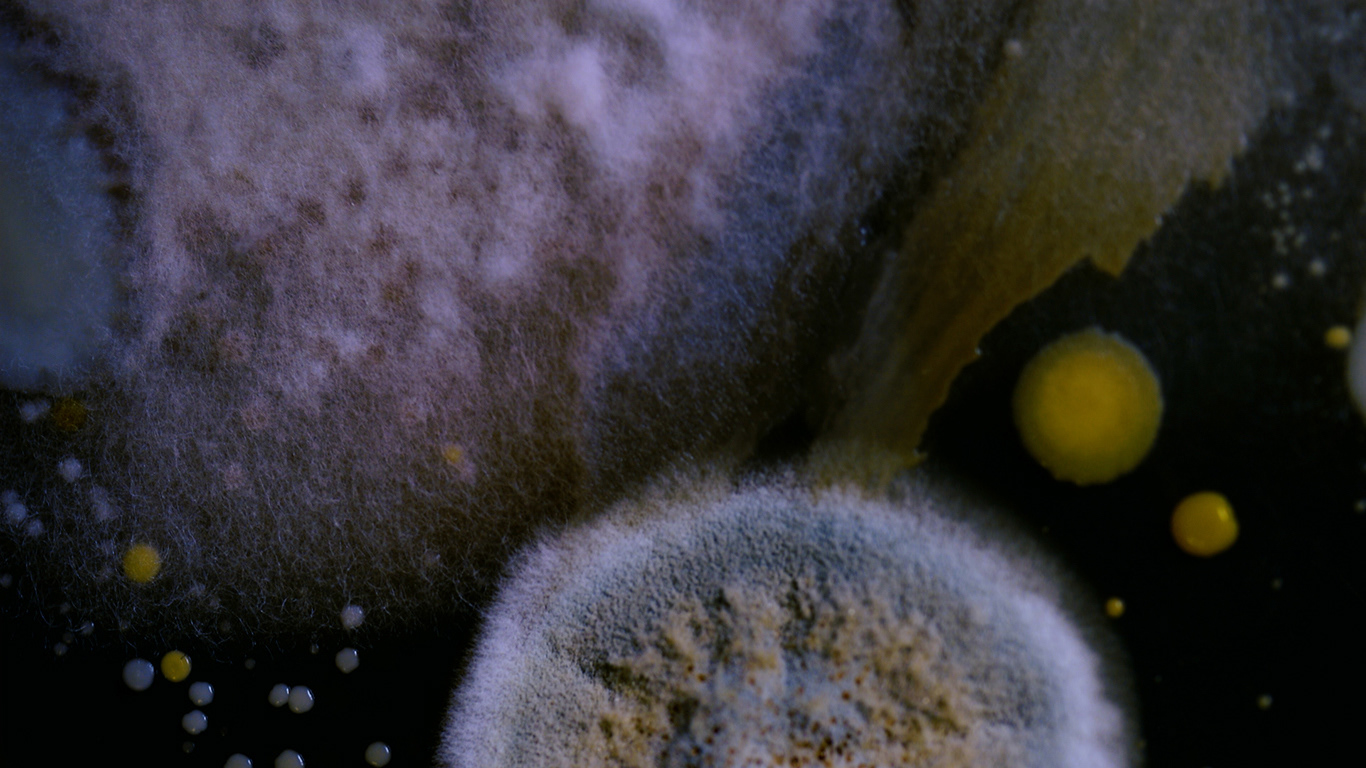
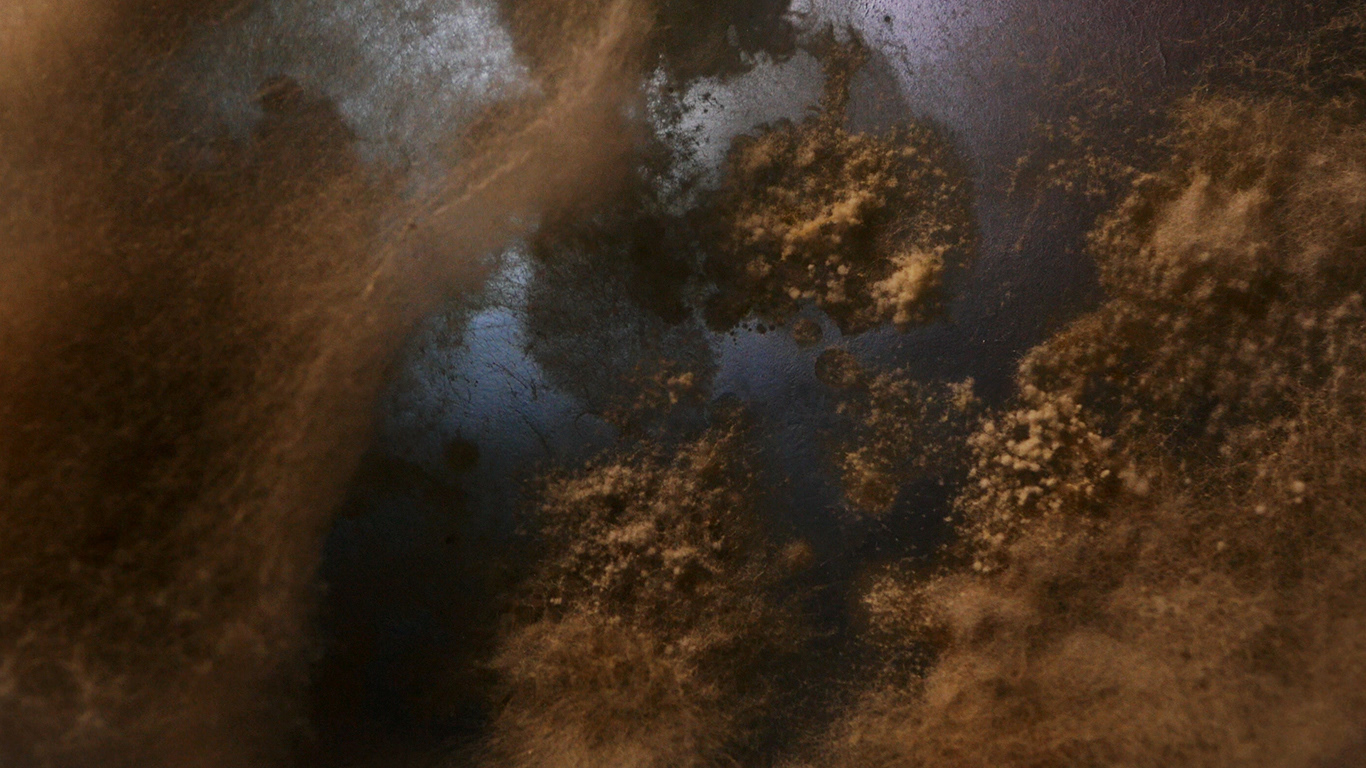

FROM THE STARS WE CAME, TO THE STARS WE SHALL RETURN
Video, 2021
15'40" Loop, HD, 16:9, color, stereo sound.
Sound Design & Music: Özcan Ertek
15'40" Loop, HD, 16:9, color, stereo sound.
Sound Design & Music: Özcan Ertek
Life begins with death. Microorganisms - such as fungi and bacteria - break down organic matter, releasing nutrients available for plants and other beings to continue growing. In this way, everything is reborn, and the whole web of life is interconnected. The idea of the Earth as an integrated whole and a self-regulating system is known as Gaia.
The origin and evolution of life are also connected in the most intimate way with the origin and evolution of the stars. When a dying star explodes, it shoots elements and debris into space. These elements travel on to form new stars, planets, and everything else in the universe. Many of the elements we find here on Earth are made in the core of stars, including those that make up the human body. The very matter we are composed of, the atoms that make life possible, were created long ago by stars in the vastness of the universe. We are made of stardust.
The video installation ‘From the Stars we Came, To the Stars We Shall Return,’ by Bruna Mayer, investigates the bacteria and fungi found in the soil of Berlin’s cemeteries in combination with organisms from her body. The artist reveals their unique shapes and patterns and brings close their microscopic nature to the vastness and infinity of galaxies and the cosmos. The work is an invitation to reflect on the relationships between the microcosm and the macrocosm, between bacteria, fungi, humans, and stars.

Video Stills